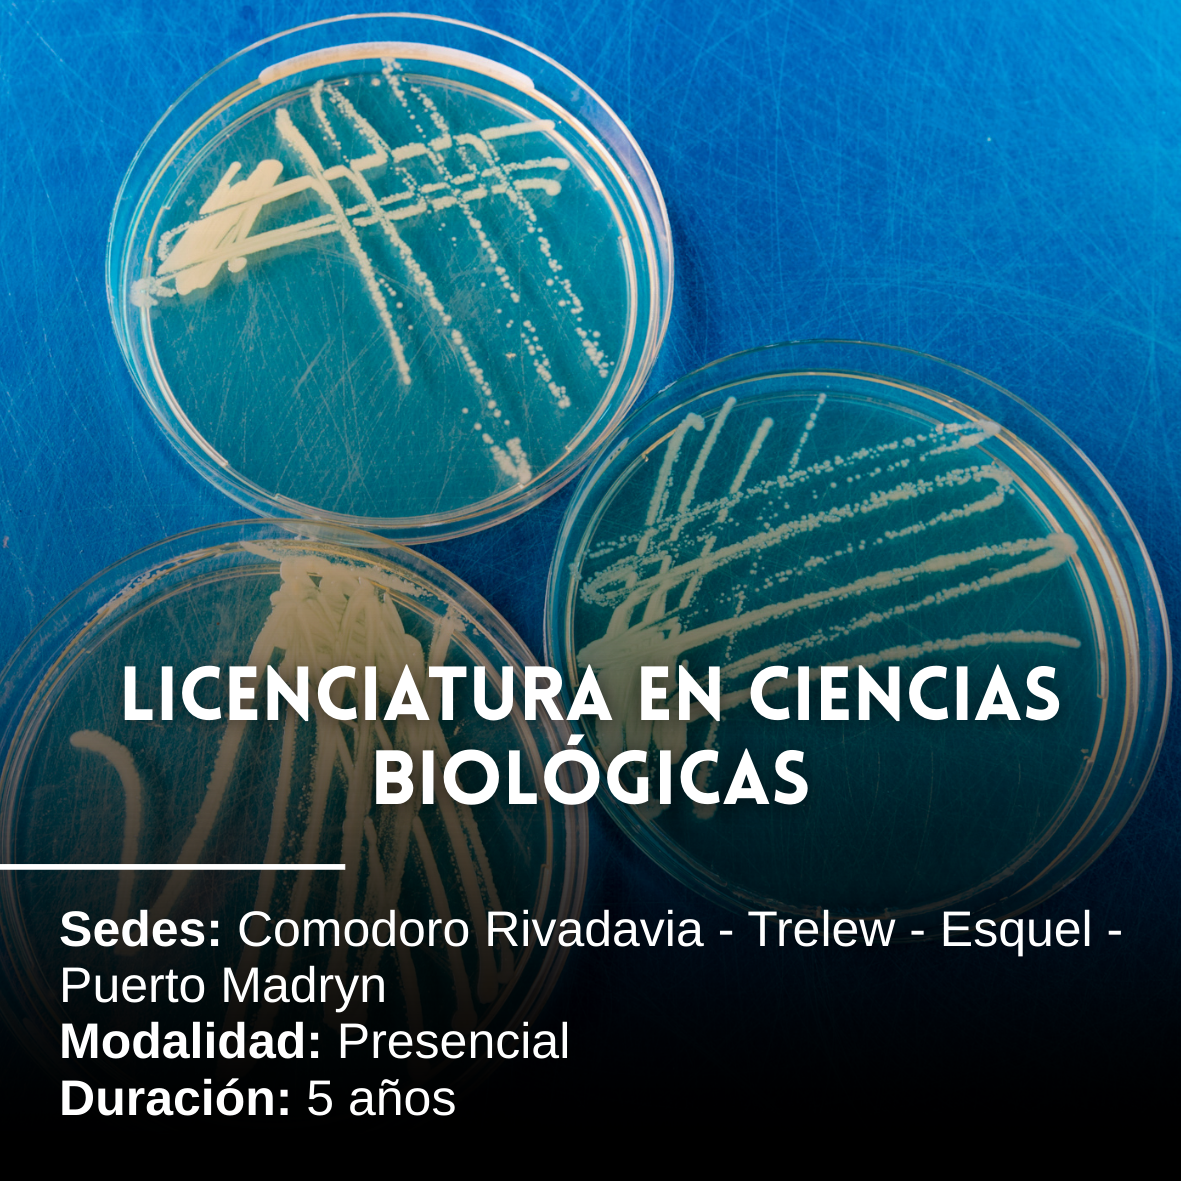
Licenciatura en Ciencias Biológicas: 5 años, Presencial, Comodoro Rivadavia, Trelew, Esquel y Puerto Madryn

¿Todavía no sabés qué estudiar? ¡No te preocupes!
La Patagonia es el escenario perfecto para tu formación profesional. En la Universidad Nacional de la Patagonia San Juan Bosco contamos con cinco facultades que cubren todas las áreas del conocimiento. Te invitamos a recorrer este portal para conocer en detalle las carreras que podés cursar en nuestras sedes de Comodoro Rivadavia, Trelew, Esquel y Puerto Madryn.
Hacé clic en la carrera que te interese y empezá a proyectar tu vida en una universidad con identidad regional y excelencia académica.
Por consultas relacionadas a información de carreras e inscripciones comunicarse con la Dirección de Orientación Educativa al WhatsApp 297 4927366.
Facultad de Humanidades y Ciencias Sociales
Facultad de Ciencias Económicas
Por Resolución Nº 176/15 las materias del Primer Año se dictan también en la Sede Puerto Madryn.
Importante: Para inscribirse a los titulos intermedios se requiere doble inscripción, tanto en la Tecnicatura como en la Licenciatura. Por lo que el formulario de preinscripción debe ser completado dos veces.
Licenciatura en Administración → Título Intermedio: Tecnicatura Universitaria en Administración.
Licenciatura en Economía → Título Intermedio: Tecnicatura Universitaria en Finanzas Empresariales.
Facultad de Ciencias Naturales y Ciencias de la Salud
Facultad de Ingeniería
Facultad de Ciencias Jurídicas
Importante:
Para el ingreso a la Tecnicatura en Criminalística, la Tecnicatura en Martillero Público y Corredor y la Licenciatura en Criminalística se encuentra supeditado a la cantidad de aspirantes inscriptos.
La Licenciatura en Criminalística – Ciclo de complementación curricular requiere título vinculante previo. Ver en Inscripciones - FCJ)